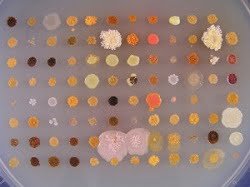

Noruega.- Por décadas, las bacterias han servido a la sociedad mediante la producción de antibióticos, el compuesto químico que puede curar las enfermedades infecciosas. Sin embargo, es posible que muchos microorganismos naturales lleven las “recetas” para las medicinas del futuro ocultas en su material genético, sin que esta parte de su código genético sea activado.
Noruega.- Por décadas, las bacterias han servido a la sociedad mediante la producción de antibióticos, el compuesto químico que puede curar las enfermedades infecciosas. Sin embargo, es posible que muchos microorganismos naturales lleven las “recetas” para las medicinas del futuro ocultas en su material genético, sin que esta parte de su código genético sea activado.
Pero ahora, los biotecnólogos de SINTEF y NTNU están desarrollando la tecnología que hará que sea más fácil encontrar, y explotar, estas fabricas de medicinas ocultas y no utilizadas en las bacterias que existen en el ambiente natural. La búsqueda se concentrará en las bacterias marinas, y este es uno de los proyecto ejecutados por el nuevo Norwegian Centre for Digital Life.
“Nuestro objetivo es identificar nuevos compuestos que sean capaces, por ejemplo, de matar las células cancerígenas o las bacterias resistentes a los antibióticos. La tecnología que estamos desarrollando reducirá el tiempo que toma la búsqueda y hará más eficiente el proceso de producción” dijo Alexander Wentzel, científico de SINTEF.
Material genético críptico
Cuando el mundo descubrió a los microorganismos que son capaces de crear sustancias que inhiben las infecciones, las propiedades naturales de estos organismos fueron el centro de atención. Los organismos seleccionados fueron cultivados para producir compuestos químicos que podrían ser aislados y que habían sido usados para combatir otros microorganismos.
Sin embargo, con la esperanza de desarrollar nuevos medicamentes para luchar contra el cáncer, y nuevos antibióticos que actúen sobre las bacterias resistentes, los científicos y la industria farmacéutica han comenzado a interesarse en el material genético que no se activan cuando las bacterias son cultivadas en el laboratorio.
El “apagado” de los genes de los microbios puede ser usados para crear útiles sustancias bioactivas que son desconocidas en la actualidad. Sin embargo, hasta ahora ha sido muy laborioso explorar esta información genética, así que los científicos se han visto obligados a buscar en un pequeño número de genes. “Aquí es donde nuestra tecnología puede ayudar” dijo Wentzel.
Búsqueda a través de muchas muestras al mismo tiempo
Mantente siempre informado
Únete a nuestras comunidades para recibir al instante las noticias, informes y análisis más importantes del sector acuícola.
La tecnología será desarrollada en el curso de los cuatro años del proyecto “INBioPharm”, el mismo que viene siendo financiada por la Research Council of Norway. Según Wentzel, las nuevas técnicas permitirán a los científicos buscar por sustancias útiles simultáneamente en un gran número de muestras.
Para ponerlo simple, los científicos serán capaces de “recortar” el material genético de un gran número de microorganismos antes de que ellos transfieran sus ADN a las bacterias cultivables; los organismos cuyas características ya vienen siendo estudiadas y serán optimizadas por los científicos en el proyecto INBioPharm. Las alteraciones permitirán que estos organismos produzcan nuevas sustancias, que no puede ser producido en los microorganismos de los cuales el ADN fue extraído.
Con la ayuda de la biología de sistemas y biología sintética, el proyecto desarrollará los microorganismos de una forma en la cual, cuando ellos sean cultivados, produzcan pequeñas cantidades de prueba de todos los productos posibles, y después, permitir la producción en masa de las sustancias más prometedoras.
La cooperación entre científicos con diferentes conocimientos, con el acceso a laboratorios avanzados, es esencial para el desarrollo de estos organismos. Además de SINTEF y NTNU, un grupo de laboratorios de primer nivel están participando en el proyecto.
Organismos no cultivables
Hasta ahora, todos los medicamentos tienen sus orígenes en los microorganismos que pueden ser cultivados. “Sin embargo, hasta el 99% de todos los microorganismos hallados en la naturaleza no pueden ser cultivados en el laboratorio. El objetivo de nuestro proyecto es utilizar también el material genético de estos organismos en la búsqueda de nuevos productos” dijo Wentzel.
Según el científico de SINTEF, hay una probabilidad significativa de que en este gran grupo de microorganismos exista material genético “no expresa” que pueda producir químicos que poseen estructuras y actividades hasta ahora desconocidos.
Contacto:
Alexander Wentzel,
Telefon: 932 00 776
Mobil:932 00 776
Epost: Alexander.Wentzel@sintef.no
SINTEF Materials and Chemistry
Editor de la revista digital AquaHoy. Biólogo Acuicultor titulado por la Universidad Nacional del Santa (UNS) y Máster en Gestión de la Ciencia y la Innovación por la Universidad Politécnica de Valencia, con diplomados en Innovación Empresarial y Gestión de la Innovación. Posee amplia experiencia en el sector acuícola y pesquero, habiendo liderado la Unidad de Innovación en Pesca del Programa Nacional de Innovación en Pesca y Acuicultura (PNIPA). Ha sido consultor senior en vigilancia tecnológica, formulador y asesor de proyectos de innovación, y docente en la UNS. Es miembro del Colegio de Biólogos del Perú y ha sido reconocido por la World Aquaculture Society (WAS) en 2016 por su aporte a la acuicultura.






